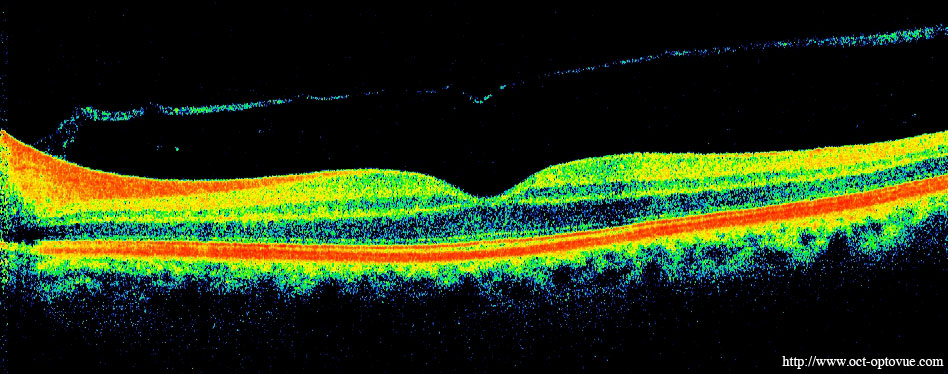
OCT image

Age-Related Macular Degeneration (AMD)
What is AMD?
The macula is the central most part of the retina, the inner layer at the back of the eye responsible for detailed central vision. It is used for reading text, driving and recognizing people’s faces. Macular degeneration is a condition that causes the center of your vision to blur while the side or peripheral vision remains clear. Macular degeneration is generally related to the aging process, and is also commonly called age-related macular degeneration (AMD). AMD is the leading cause of blindness in North America in adults over the age of 55.
Symptoms of AMD
In the earliest stages of the disease, AMD is symptom free but we can detect it during comprehensive eye health examinations.
The first symptom that a person might notice is slightly blurred central vision when performing tasks that require seeing detail or a sensation that there is dirt or a smudge getting in the way of clear vision. Glasses cannot correct this blurred spot. Over time, the blurred area may increase in size and interfere with reading and recognizing faces. Other symptoms of AMD can cause straight lines to look wavy or distorted, and dark spots may blank out portions of the central vision. Patients experience no pain with AMD.
Diagnosis
One of the ways we diagnose AMD is by using a colour retinal camera, known as fundus photography. Fundus photography captures an image of your retina, optic disc, macula and posetrior pole. The resulting image can document the presence of diseases such as AMD and others including deabetic retinopathy, macular edema and retinal detatchment. This is what a fundus photograph looks like:

We also use optical coherence tomography (OCT), an imaging technique that uses infrared light reflections off the retina to genrate a cross-sectional view of the retinal tissue. These images can show evidence of AMD and thinning of the retina caused by cell death associated with AMD. This is what an OCT image looks like:
AMD Risk Factors
AMD risk factors include, increasing age, smoking, and UV exposure. AMD is also associated with high blood pressure, arteriosclerosis, and a family history of AMD.
Preventing AMD
Using good, life-long UV eye protection and good nutrition are believed to help prevent AMD. Living a healthy lifestyle by keeping your blood pressure down, reducing your intake of fatty foods and not smoking can also help. A diet high in antioxidants such as beta-carotene (a form of vitamin A), vitamins C and E, zinc, lutein, zeaxanthin, selenium and omega 3 fatty acids may help prevent AMD may also be of benefit. Most of these antioxidants are found in fruits and leafy green vegetables. Regular eye examinations are also important in the early detection of AMD; we can find early signs even before you experience symptoms. We can then discuss ways to minimize the possibility of vision loss due to AMD.
Help for patients who have already lost vision to AMD
At Perspective Optometry, we offer low vision aids that can help patients maximize their remaining vision so that that the lifestyle impact of AMD can be minized as much as possible.